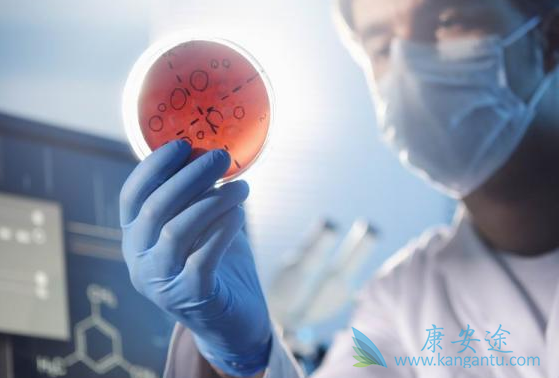
丙肝好治吗 丙肝好治吗

丙肝的治疗最关键的就是抗病毒治疗,但是方式和时期很关键,丙肝治疗要得到较好的疗效必须注意以下事项:首先丙肝防治“三早”很关键,即早检测,早诊断,早治疗。如果已经明确诊断为丙肝,就要尽早开始正规治疗;坚持治疗,切莫擅自更改治疗方案和擅自停药;正确处理治疗的不良反应。那慢性丙肝好治吗?
答案是肯定的,慢性丙肝好治,尤其处于早期的丙肝患者,丙肝新药吉三代的有效率在99%,而且副作用很小,患者只需每日口服一片,3个月就可以治愈丙肝。对于晚期肝癌,也就是出现肝硬化的丙肝患者,需要将吉三代与利巴韦林联合,治疗事件延长至半年,就可以治愈丙肝。当然,丙肝患者在治疗期间需严格按照医生的要求,不可擅自停药,减药,加药。
那如果丙肝不治疗有什么危害?丙肝的危害可怕在它的隐匿性,因为很多丙肝患者都是在体检中发现的,所以丙肝被称为“沉默的杀手”。有调查发现,目前丙肝“稳居”传染病患者人数的第四位,平均每100人大约有3人曾经感染过丙肝,但是真正因为丙肝到医院就诊的只有10%,逾九成患者漏诊,但疾病却在不知不觉中持续进展,多数患者常在疾病发展到晚期时才被发现,错过了最佳治疗时机,甚至发展为肝硬化或肝癌。
详情请访问 丙肝 http://www.kangantu.org/
















请简单描述您的疾病情况,我们会有专业的医学博士免费为您解答问题(24小时内进行电话回访)